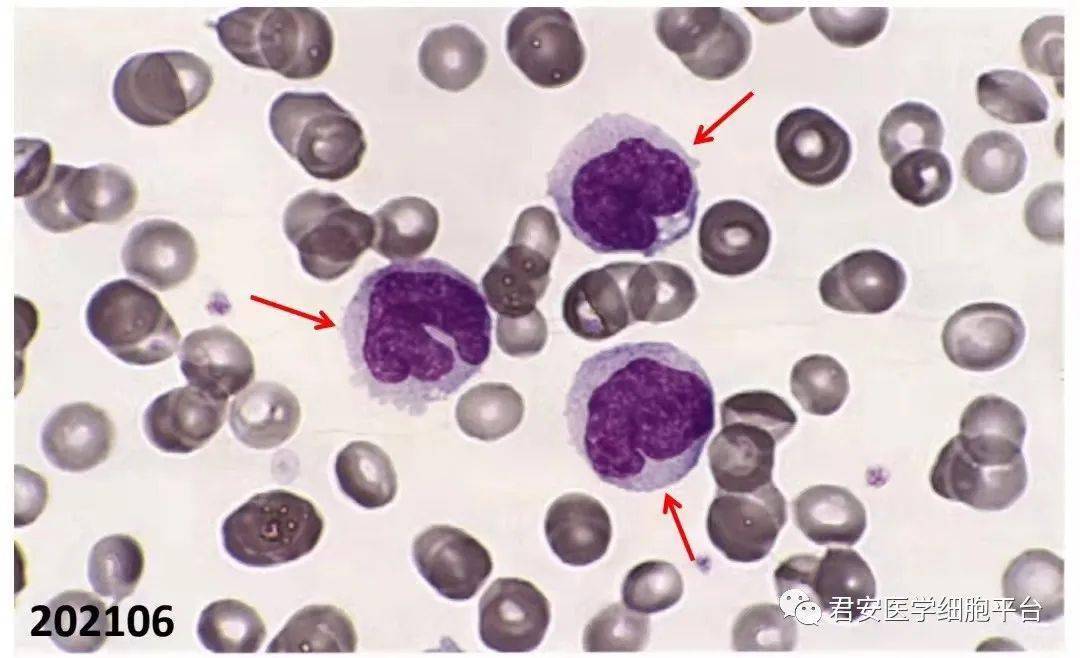
外周血涂片 瑞氏-吉姆萨染色 1000x202106卡波氏环(cabot ring)点击

血涂片报告单

发现白细胞数减低,部分粒细胞颗粒稍粗,可见空泡变性,血涂片报告如图
图片尺寸708x409
一份外周血涂片弄清血常规异常结果
图片尺寸1080x1085
西安市儿童医院小小血涂片发现大问题
图片尺寸560x336
骨髓报告单骨髓细胞涂片外周血形态特征:胞体较小的原始细胞形态似
图片尺寸1080x1320
mds-bitp53_检测_基因_患者
图片尺寸1080x1320
四川省妇幼保健院的外周血脊肌萎缩症检测知情同意书上这样写道:[脊肌
图片尺寸550x658
中碳能投等机构碳排放报告数据弄虚作假等典型案例公布
图片尺寸692x575
染色体核型分析流式细胞骨髓报告单骨髓细胞涂片外周血形态特征:胞体
图片尺寸1080x1064
干细胞治疗糖尿病视网膜病变丨不仅改善视力,视觉,还具有明显的降血糖
图片尺寸655x518
图片浏览
图片尺寸482x395
血球仪图册_百度百科
图片尺寸220x157
一位缺铁性贫血患者的外周血涂片
图片尺寸220x165
大赛设有笔试,抢答两个理论环节和兔胃切开手术,徒手打结,血涂片的
图片尺寸1080x607
浅谈蛋鸡白冠病及精准安全防控
图片尺寸1242x1700
节后减肥需注意减肥不当容易患上贫血
图片尺寸529x545
替尼,赛沃替尼和含铂化疗,多发肺和左股骨转移,外周血检测结果为egfr
图片尺寸869x330
外周血涂片 瑞氏-吉姆萨染色 1000x202106卡波氏环(cabot ring)点击
图片尺寸1080x658
完成烹饪小贴士:1,猪肉含有丰富的优质蛋白质和必需的脂肪酸,并提供
图片尺寸660x368
毛细胞性白血病图片_百度百科
图片尺寸203x250
男足输球上热搜巾帼累瘫无人问
图片尺寸900x1072
猜你喜欢:正常血涂片报告单正常血涂片报告单图片正常血涂片报告单模板血涂片报告单图片血涂片报告血检报告单血清外周血涂片报告单血涂片报告单读懂外周血涂片报告单图片骨髓涂片报告单血涂片报告模板血检报告单血检报告单图片正常骨髓涂片报告单血检报告单正常血涂片人血涂片标准血涂片外周血涂片外周血检查报告单图片骨髓报告单图片人血永久涂片血涂片细胞形态图片血涂片显微镜血涂片制作血涂片实验报告画图血检hcg报告单图片人血永久涂片图片血涂片各种细胞的图片血检报告舞台灯光设计平面图16张纸折一个灯笼手绘足球海报简单云梯消防车构造女生头像洛丽塔真人3.8米的客厅装修效果图自动变速箱内部图解打哈欠图片动漫卡通人物三视图中国特高压输电线路图aph芋兄弟灰色地砖贴图素材